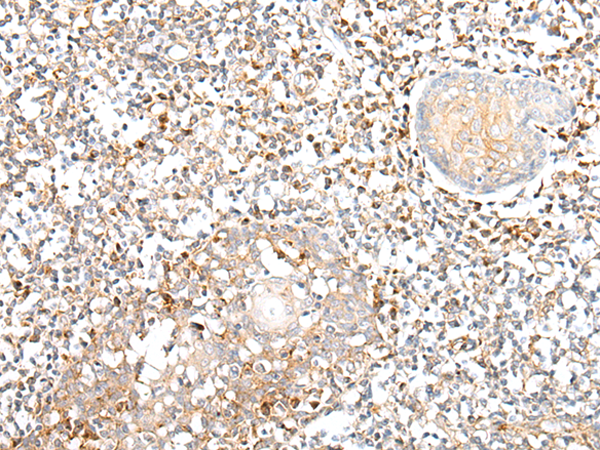

别名:EFL4; EPLG4; LERK4应用:IHC
反应种属:Human, Mouse
规格:50μl/100μl
| Description |
|---|
| This gene encodes a member of the ephrin (EPH) family. The ephrins and EPH-related receptors comprise the largest subfamily of receptor protein-tyrosine kinases and have been implicated in mediating developmental events, especially in the nervous system and in erythropoiesis. Based on their structures and sequence relationships, ephrins are divided into the ephrin-A (EFNA) class, which are anchored to the membrane by a glycosylphosphatidylinositol linkage, and the ephrin-B (EFNB) class, which are transmembrane proteins. This gene encodes an EFNA class ephrin. Three transcript variants that encode distinct proteins have been identified. |
| Specification | |
|---|---|
| Aliases | EFL4; EPLG4; LERK4 |
| Swissprot | P52798 |
| Host/Isotype | Rabbit IgG |
| Storage | Store at 4°C short term. Aliquot and store at -20°C long term. Avoid freeze/thaw cycles. |
| Species Reactivity | Human, Mouse |
| Immunogen | Synthetic peptide of human EFNA4 |
| Formulation | pH7.4 PBS, 0.05% NaN3, 40% Glycerol |
| Application | |
|---|---|
| IHC | 1/25-1/100 |
| ELISA | 1/5000-1/10000 |
![]() |
The image is immunohistochemistry of paraffin-embedded Human cervical cancer tissue using P05759(EFNA4 Antibody) at dilution 1/30. (Original magnification: ×200) |
![]() |
The image is immunohistochemistry of paraffin-embedded Human tonsil tissue using P05759(EFNA4 Antibody) at dilution 1/30. (Original magnification: ×200) |
本公司的所有产品仅用于科学研究或者工业应用等非医疗目的,不可用于人类或动物的临床诊断或治疗,非药用,非食用。
暂无评论
本公司的所有产品仅用于科学研究或者工业应用等非医疗目的,不可用于人类或动物的临床诊断或治疗,非药用,非食用。
中文

发表回复